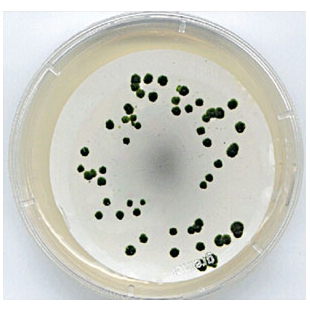
Placa Conica

Descrição
Digitalização de imagens de Géis de Eletroforese • SDS PAGE • Western Blotting colorimétrico • Autorradiografias
O Densitômetro DS-5000 é um scanner de géis e amostras laboratoriais, equipado com um suporte removível que permite fácil lavagem ou limpeza. Compatível com amostras coradas com substâncias colorimétricas, as digitalizações são feitas com rapidez e alta qualidade. Promove praticidade no manuseio e facilidade na análise dos resultados.
Apresenta 2 plataformas de digitalização: uma para amostras translúcidas (géis, placas, autorradiografias etc) compatível com amostras úmidas, e outra para amostras opacas e secas (membranas, documentos em papel, folhas de plantas, gráficos e dados impressos).
Sistema para digitalização de imagens de:
- Géis de eletroforese 2D
- Géis de DGGE
- Géis corados com nitrato de prata
- Géis corados com Coomassie Blue
- Autorradiografias
- Placas de Colônias
- Membranas coradas com vermelho de Ponceau
- Membranas e Blots Colorimétricoss
CARACTERÍSTICAS
- Escaneia uma amostra em até 6 segundos.
- Digitalização de amostras secas ou úmidas.
- Aparato removível em caso de amostras úmidas.
- Áreas de digitalização de 216 x 356 mm (reflexiva) e de 216 x 254 mm (transparente).
- Acompanha software de captura de imagens, L-Pix DS.
- Produz imagens de alta qualidade: 4800 dpi.i.
Inclui software de captura e edição de imagens para ser instalado no computador que controlará o sistema.
Software de quantificação de bandas e densitometria LabImage 1D pode ser adquirido como acessório opcional.
Software para contagem automática de colônias de bactérias LabImage CC também é um acessório opcional.
Produto destinado exclusivamente à utilização em pesquisa científica.